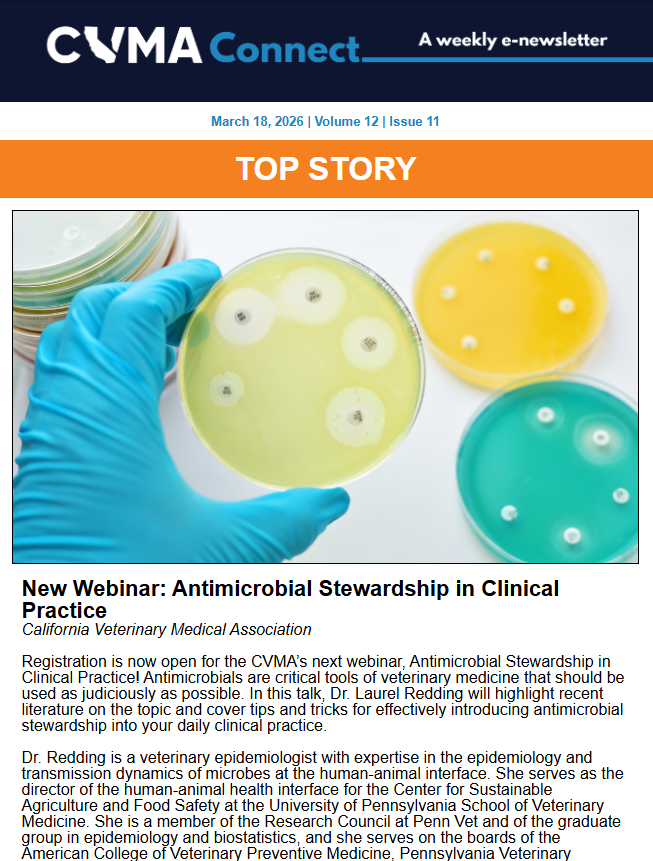

If you are having trouble logging in to your account, it may be a pop-up issue. Click here for more information.
If you are having trouble logging in to your account, it may be a pop-up issue. Click here for more information.
Contact Erica Ferrier at 916-649-0599 for advertising inquiries.
Download a Media Kit.
Members
The California Veterinary Medical Association (CVMA) is the largest state veterinary medical association in the nation with more than 7,000 members.
The veterinary community has relied upon the CVMA since its inception in 1888 to represent and advocate for the profession. We are entrusted to provide the most reputable, up-to-date information about veterinary medicine and act as a resource of support and news for our members and the veterinary profession more broadly—and we deliver!

Backed by the CVMA’s long-standing authority and reputation in California and beyond, advertising through the CVMA will help expand your influence in the realm of veterinary medicine.

The CVMA offers both print and digital advertising opportunities. Ad space is offered in a variety of sizes and options to fit your budget, ensuring that your message will reach veterinary professionals across the state without breaking the bank.
The CVMA’s California Veterinarian Magazine boasts the largest circulation of any state veterinary publication with a circulation of 13,500. It is mailed bi-monthly to all 7,000 CVMA members as well as all licensed California veterinary practitioners, reaching veterinarians of all practice types. Additionally, it is sent to veterinary academia, such as veterinary school faculty, researchers, and veterinary students.
Connect, the CVMA’s e-newsletter, sent out every Wednesday to all CVMA members, includes the most up-to-date information about issues relevant to the veterinary profession, member benefits, and continuing education. Advertisement is a banner ad, which is hyperlinked to the company website. Space is limited to three advertisements per Connect, ensuring that your ad will be seen.
![]() Average open rate of 64.7%
Average open rate of 64.7%
![]() Average click-through rate of 3%
Average click-through rate of 3%
This monthly email, which details all “Upcoming CE” events put on by the CVMA, is sent to approximately 22,000 recipients each month. Advertisement is a banner ad, which is hyperlinked to the company website. Space is limited to two advertisements per e-blast.
![]() Average open rate of 55.25%
Average open rate of 55.25%
![]() Average click-through rate of 3.75%
Average click-through rate of 3.75%